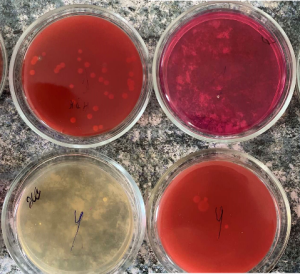
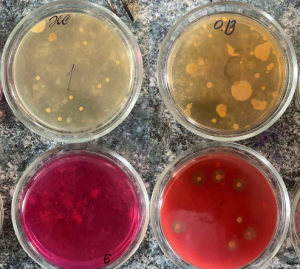

EDUCATIONAL AND RESEARCH INSTITUTE OF BIOMEDICAL PROBLEMS
Educational and Research Institute of Biomedical Problems of Ivan Horbachevsky Ternopil National Medical University of the Ministry of Health of Ukraine was established by the Order of the Rector of the University No. 201 dated June 8, 2005 and has been functioning since July 15, 2005. The Institute is a structural unit of the University located at 2 Slovatsky Street, and includes 5 departments: Department of Medical Biology; Department of Microbiology, Virology and Immunology; Department of Physiology, Bioethics and Biosafety; Department of Public Health and Healthcare Management; Department of Physical Therapy, Occupational Therapy and Physical Education (located in the Dormitory No.4). From 2013 to 2016, the Department of Medical Law was part of the Institute of Biomedical Problems.
The Institute of Biomedical Problems has a staff of 11 Doctors of Science in Medicine, 1 Doctor of Science in Veterinary Medicine, 25 PhDs in Medicine, 14 PhDs in Biology, 2 PhDs in Pedagogy, 2 PhDs in Economics, 1 PhD in Pharmacy, 1 PhD in Philology, 1 PhD in Geography, and 1 PhD in Philosophy (Theology).
The Institute of Biomedical Problems consists of the following departments:
Department of Medical Biology
Department of Microbiology, Virology and Immunology
Department of Physiology, Bioethics and Biosafety
Department of Public Health and Healthcare Management
Department of Physical Therapy, Occupational Therapy and Physical Education

Director of the Institute

Deputy Director of Educational work

Deputy Director of Scientific work
Both domestic and international students from four faculties study at the departments of the Institute of Biomedical Problems. Classes involving international students are taught by 36 English-speaking teachers, including 8 teachers holding B2 level certificates of English proficiency: Prof. Hanna Saturska, Assoc. Prof. Iryna Halabitska (Department of Microbiology), Assoc. Prof. Iryna Pryvrotska (Department of Medical Biology), Prof. Nataliia Volkova, Assoc. Prof. Sofiia Nakonechna (Department of Physiology), Prof. Dariia Popovych (Department of Physical Therapy); at the C2 level: Assoc. Prof. Yurii Petrashyk; and at the C1 level: Assoc. Prof. Kateryna Myndziv (Department of Physical Therapy) and Assoc. Prof. Taras Piatkovsky (Department of Microbiology).
The Institute provides a range of facilities to support training and research. It has a total of 38 classrooms for training purposes, along with two lecture halls. Additionally, there is a mini-library available for students’ use. For physical fitness and exercise, the Institute offers two workout rooms, a gym, and a fitness room. A dedicated computer room is available for computer-based activities. In terms of research facilities, the Institute houses a microbiological and parasitological research laboratory. Furthermore, it boasts the I. Yaremenko Educational Biological Museum, which serves as an educational resource for students.

Computer classroom

The use of multimedia presentations and video fragments in the learning process during practical classes
The use of an interactive whiteboard in the learning process. Fitness center. Office of occupational therapy
The Institute has developed over 26 virtual training and testing computer programs specifically designed for students. These programs offer interactive and immersive learning experiences, allowing students to practice and test their knowledge in a virtual environment. Additionally, there are more than 140 educational and popular science videos that are accessible through video systems during lectures, practical classes, and students’ independent study sessions. These videos cover various topics from relevant courses and greatly enhance students’ interest in comprehending the material. Moreover, the University’s web portal on the Intranet system provides access to around 8000 educational resources. These materials serve as valuable learning aids, supporting students’ understanding and further exploration of the subjects. The lecturers at the Institute have made an effort to provide comprehensive resources for students by recording and posting YouTube video lectures in two languages. Specifically, the Department of Medical Biology has recorded 120 video lectures in Ukrainian and 45 in English; the Department of Microbiology, Virology and Immunology has recorded 103 video lectures in Ukrainian and 50 in English; the Department of Physiology, Bioethics and Biosafety has recorded 136 video lectures in Ukrainian and English.
The ongoing COVID-19 pandemic and the effects of the war have necessitated a shift in the training methods for students, requiring remote or mixed-format education. In response, the departments of the Institute have taken significant measures to enhance the quality of practical classes during this challenging period. In addition to utilizing their own teaching materials, such as databases of teaching and learning complexes and video lectures recorded by teachers, international educational platforms like ELSEVIER HEALTH, AMBOSS, EBSCO, and Lecturio have been instrumental in supporting the educational process. Notably, the owners of these platforms have provided free access to their resources as a gesture of support during the war. This collaboration with international platforms has enriched the educational experience by offering a wider range of learning materials and resources, aiding students in their studies despite the challenging circumstances.
Practical class in the elective course “Fundamentals of ultrasound diagnostics” (2021)
Registration of visual potentials demonstrated using a computer DX complex at a meeting of the Student Scientific Club of the Department of Physiology, Bioethics and Biosafety
In recent years, renovations and improvements have been made to the premises of the Institute of Biomedical Problems, enhancing the overall infrastructure and environment. Academic years 2019-2021
To address the issue of basement flooding, paving stones were installed in front of the entrance to the building. This measure helps to prevent water accumulation and protects the basement from potential water damage. Additionally, two entrance doors leading to the building courtyard were replaced with new ones. These doors not only serve as regular entry points but also function as emergency exits when necessary. Furthermore, a gate was installed to secure the courtyard area, providing controlled access and ensuring the safety of the premises.
Academic year 2021-2022
In order to ensure the safety of students and create secure learning conditions during martial law, the Institute of Biomedical Problems took proactive measures. Within the building, shelters capable of accommodating 170 and 250 individuals were prepared. The stairs leading to these shelters were repaired, ensuring safe and easy access. Washbasins and sanitary facilities were also installed to provide necessary hygiene amenities. Additionally, benches for 450 people were brought in, allowing individuals to rest and gather in a designated area.
Anti-radiation shelter
The Institute places significant emphasis on the activities of the Student Scientific Club, which operates actively across all departments. Each year, teachers from the Institute’s departments provide guidance and support for the Club’s research projects, training students for various competitions and contests as well as national and international medical congresses of students and young scientists, where students receive prizes and awards.

Students-winners of the International Competition “Samarkand—2020” (2021)

Winners of the All-Ukrainian Competition of Student Research Papers in the Theoretical Medicine section: Yaroslav Bilyk, Sofiia Chornii (2022).
In addition to the meetings of the Scientific Club, members of the Club are actively involved in the work of research groups in Ternopil secondary schools

Pupils of Ternopil secondary schools and students of TNMU during environmental events “Magic of the Earth’s Elements”, “Fire is a Friend, Fire is an Enemy”, “Who needs Air?”, “Water is Life” (2021)
Established in 1957, the I. Yaremenko Educational Biological Museum serves as a valuable resource for the educational process. Within the Museum, a mini-lecture hall has been set up, equipped with multimedia facilities to deliver lectures using engaging multimedia presentations. The Museum also hosts training seminars that include the presentation of scientific and educational videos, further enriching students’ knowledge and understanding. Moreover, the Museum serves as a venue for presenting scientific reports during sectional meetings held at scientific and practical conferences.
The I.Yaremenko Educational Biological Museum

The departments are provided with the textbooks and manuals necessary for teaching purposes, and in order to replenish the libraries with modern educational materials adapted to the educational process, creative teams are formed at the departments of the Institute to prepare and publish them. Teachers of the Institute of Biomedical Problems are authors and co-authors of more than 20 monographs, about 30 textbooks on relevant subjects, as well as 50 manuals—both in Ukrainian and English—which are used in the educational process of I-IV accreditation level higher education institutions of the Ministry of Health of Ukraine.
Textbooks and manuals
Sponsorship: 30 textbooks were donated to the TNMU library. 30 textbooks were sent to the Department of Microbiology of Donetsk National Medical University.
The Institute’s scientific work involves planning and implementation of PhD thesis and research, organization and participation in national and international scientific forums, and maintenance of the Microbiological and Parasitological Research Laboratory. The Institute of Biomedical Problems has successfully established two scientific laboratories, one at the Department of Physiology, Bioethics, and Biosafety, and the other at the Department of Microbiology, Virology, and Immunology. In the Laboratory of Psychophysiological Research located at the Department, research was conducted in accordance with the Department’s planned scientific work “Psychophysiological aspects of adaptation of young people in the conditions of global warming”. In March 2003, the Microbiological and Parasitological Research Laboratory was established at the Institute of Biomedical Problems. It has undergone state accreditation and obtained the certificate granting it the authority to employ measurement methods.
Microbiological and Parasitological Research Laboratory
The staff at the Microbiological and Parasitological Research Laboratory focuses on various areas of scientific interest. These include studying the microbial ecology of humans across different age groups, both in normal and pathological conditions; adhesive, antagonistic, anticomplementary properties of microorganisms; antibiotic sensitivity of bacteria; the impact of microorganisms on the development of somatic diseases; problems of probiotics in medicine, helminthiasis. The laboratory plays a crucial role in conducting sanitary and preventive examinations for employees and students from all faculties of the University. This involves performing over 6,000 bacteriological tests to identify carriers of Staphylococcus aureus and pathogenic enterobacteria. Furthermore, more than 3,000 parasitological tests are conducted. The laboratory also engages in scheduled research activities and contributes to the work of doctoral candidates pursuing their PhD theses.

The Department of Microbiology, Virology, and Immunology actively collaborates with the bacteriological laboratories of the University Hospital to investigate multidrug-resistant bacterial strains using the Vitek Compact-2 bacterial analyzer and to monitor antibiotic resistance and antibiotic sensitivity of microorganisms using WHOOLE-net systems.


The Institute organizes an annual scientific and practical conference called “Environment and Health,” which has been held at TNMU for fifteen consecutive years. This significant event is dedicated to commemorating the victims of the Chernobyl nuclear power plant accident. Under the guidance of Professor Stepan Vadziuk, the conference brings together a diverse array of participants, including over 220 scientists from various regions of Ukraine. The conference attracts participants from a wide geographical range, including Lutsk, Uzhhorod, Ivano-Frankivsk, Lviv, Kyiv, Dnipro, Chernivtsi, Vinnytsia, and Ternopil. These participants represent a range of institutions, including medical universities, colleges, pedagogical universities and schools, sanitary and epidemiological facilities, departments of ecology and natural resources, as well as research institutes. 

Participants of the scientific symposium with international participation “Public Health in the Global and Regional Space: Challenges in the Context of the COVID-19 Pandemic and Prospects for Development”. (2021)
Our University hosted an All-Ukrainian scientific and practical conference with international participation “Prospects for the Development of Medical and Physical Rehabilitation at Different Levels of Medical Care” (2021). The event was organized by the Departments of Medical Rehabilitation and Physical Therapy, Occupational Therapy and Physical Education. It was attended by leading experts from all over Ukraine, including Kramatorsk, Rivne, Odesa, Lviv, Lutsk, Ivano-Frankivsk, etc. During the meetings, 44 scientific reports were heard and discussed.
Міжнародні стажування

Participation in a seminar within the project titled “Rethinking Pedagogy for Implementing Sustainable Development Education in the Baltic University Program Countries”, Tallinn (Estonia), (2019)
Assoc. Prof. Lidiia Romaniuk, Assoc. Prof. Nataliia Kravets and Assoc. Prof. Nina Oliinyk —participants of the PRO/PRE BIOTIC II Congress, Kyiv (2020)
Prof. Larysa Fedoniuk during an internship in Rzeszow (Poland) within the framework of the international project “Four Elements of Nature—Harmony of Life in the Ternopil Region and Podkarpackie Voivodeship” (2022)
Assoc. Prof. Olena Pokryshko at the 7th Euro-Mediterranean Conference “LifeSciences, Pharma, and Biomedicine” (BioNat-7), Cairo, Egypt (2021)


Assoc. Prof. Oksana Zahrychuk completed her international internship on “Internationalization of Educational Institutions: International Projects and Partnerships” (2021)
Professor of the Department of Microbiology, Virology and Immunology Kamyshnyi O.M. took part in a meeting with Dr. Sandor G. Vari (Dr. Sandor G. Vari) – director of international scientific and innovation programs at the Cedars-Sinai Medical Center (Cedars-Sinai Medical Center, Los Angeles, CA, USA) and president of the RECOOP HST Association

Professor Dariia Popovych of the Department of Physical Therapy, Occupational Therapy during a professional internship at the General Faculty Hospital of Charles University in Prague.
Over the past 5 years, the Institute has been engaged in research work on the following topics:
The staff of the Institute has received more than 80 patents for inventions, published more than 1000 publications in journals and collections of articles, including more than 100 in Scopus and Web of Science scientific and metric databases. Currently, the Institute’s staff is working on 3 doctoral and some 10 PhD theses. In 2015, in the Psychophysiological Laboratory of the Department of Physiology, the Research Center “Institute of Age Physiology” was established, led by Prof. Stepan Vadziuk, Honored Worker of Science and Technology of Ukraine, Doctor of Science in Medicine. At present, creative cooperation is carried out with the H. Kostiuk Institute of Psychology of the National Academy of Pedagogical Sciences of Ukraine, the Ukrainian Medical and Dental Academy, and departments of Ivan Horbachevsky Ternopil National Medical University of the Ministry of Health of Ukraine. Teachers of all departments of the Institute are actively engaged in national-patriotic, intellectual and spiritual, historical and ecological education of students.
Students of the Faculty of Dentistry on a tour of the dungeon of the Archdiocesan Cathedral (2023)
Students of the Faculty of Medicine on an excursion to the Historical and Memorial Museum of Political Prisoners (2022)
First-year students of the Faculty of Medicine on an excursion to the Ivan Horbachevsky Museum-Estate in the village of Zarubyntsi (2019)


Students of the Faculty of Dentistry at a performance in the Ternopil Drama Theater (2020)
Ukraine has been courageously resisting a full-scale invasion by the Russian army for an extended period of time. In these challenging circumstances, providing comprehensive support, both in terms of resources and technical assistance, is crucial for the ongoing combat operations. Driven by a strong desire for positive change and the opportunity to contribute, the Institute’s employees have actively taken part in volunteer work to aid the Armed Forces of Ukraine. Their dedication reflects a collective commitment to making a difference and supporting the country’s defense efforts.
Assist. Prof. Ihor Medvid in the Volunteer Center
of the Ternopil National Medical University (2022)
Assoc. Prof. Stepan Podobivsky at a meeting with a representative of the Armed Forces of Ukraine (2022)
Employees of the Department of Public Health and Healthcare Management making trench candles “Give warmth to our defenders” (2022)
On the initiative of students of the 3rd year of med. the teaching staff and employees of the Institute of Medical and Biological Problems collected waste paper, all proceeds (over UAH 2,300) were transferred to the volunteer center
During its history, the directors of the Educational and Research Institute in different years were:
1995-2012 — Doctor of Science in Medicine, Prof. Stepan Vadziuk;
2012-2013 — Doctor of Science in Medicine, Prof. Serhii Klymniuk;
2013-2015 — Doctor of Science in Medicine, Prof. Larysa Fedoniuk;
2015-2016 — Doctor of Science in Medicine, Prof. Оleksandr Holiachenko;
since 2016 — PhD in Medicine, Assoc. Prof. Nataliia Tkachuk.